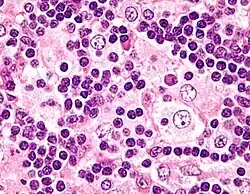

Emperipolesis
Micrograph showing emperipolesis in a case of Rosai-Dorfman disease. H&E stain.
Emperipolesis is the presence of an intact cell within the cytoplasm of another cell.[1] It is derived from Greek (en is inside, peripoleomai is go round).[2] Emperipolesis is an uncommon biological process, and can be physiological or pathological.[3]
It is related to peripolesis, which is the attachment of one cell to another.[4]
Emperipolesis is unlike phagocytosis, in which the engulfed cell is killed by the lysosomal enzymes of the macrophage. Instead, the engulfed cell remains viable within the other, and can exit at any time without causing structural or functional abnormalities in either cell.[3]
Classification
Emperipolesis has been classified into two categories:[3]
- Engulfment of hemapoietic cells by megakaryocytes such as in hematolymphoid disorders (Hodgkin's disease, leukemia, acute and chronic myeloid leukemia, non-Hodgkin's lymphoma, myeloproliferative disorders, myelodysplastic syndrome)
- Engulfment of inflammatory cells by histiocytes, which is a hallmark of Rosai-Dorfman disease[5]
Other associations
It is seen in various conditions including:
- Autoimmune hepatitis[6]
- Leukocyte migration from the blood stream to tissues through endothelial cells, in a process also known as transcellular migration and is akin to diapedesis (paracellular migration).
Additional images
Emperipolesis: a band neutrophil inside a megakaryocyte (Wright-Giemsa, 100x, oil).
Emperipolesis in Rosai-Dorfman disease highlighted by S-100 staining.
Emperipolesis: Megakaryocyte containing a segmented neutrophil, stained with a May-Grünwald Giemsa stain.
See also
- Hemophagocytic syndrome
- Phagocytosis
- Symbiogenesis
- Entosis
References
- ↑ Emperipolesis. dictionary.com. URL: http://dictionary.reference.com/browse/emperipolesis. Accessed on: 11 August 2010.
- ↑ Emperipolesis. Stedman's Medical Dictionary. 27th Ed.
- 1 2 3 Rastogi, Varun; Sharma, Rachna; Misra, Satya; Yadav, Lalita; Sharma, Vandana (2014). "Emperipolesis – A Review". Journal of Clinical and Diagnostic Research. 8 (12): ZM01 – ZM02. doi:10.7860/jcdr/2014/10361.5299. PMC 4316366. PMID 25654060.
- ↑ Lyons DJ, Gautam A, Clark J, et al. (January 1992). "Lymphocyte macrophage interactions: peripolesis of human alveolar macrophages". Eur. Respir. J. 5 (1): 59–66. PMID 1577151.
- ↑ Demicco EG, Rosenberg AE, Björnsson J, Rybak LD, Unni KK, Nielsen GP (July 2010). "Primary Rosai-Dorfman Disease of Bone: A Clinicopathologic Study of 15 Cases". Am J Surg Pathol. 34 (9): 1324–1333. doi:10.1097/PAS.0b013e3181ea50b2. PMID 20679880. S2CID 36359545.
- ↑ Covelli C, Sacchi D, Sarcognato S, Cazzagon N, Grillo F, Baciorri F, Fanni D, Cacciatore M, Maffeis V, Guido M (2021). "Pathology of autoimmune hepatitis". Pathologica. 113 (3): 185–193. doi:10.32074/1591-951X-241. PMC 8299324. PMID 34294936.
This article is issued from Wikipedia. The text is licensed under Creative Commons - Attribution - Sharealike. Additional terms may apply for the media files.